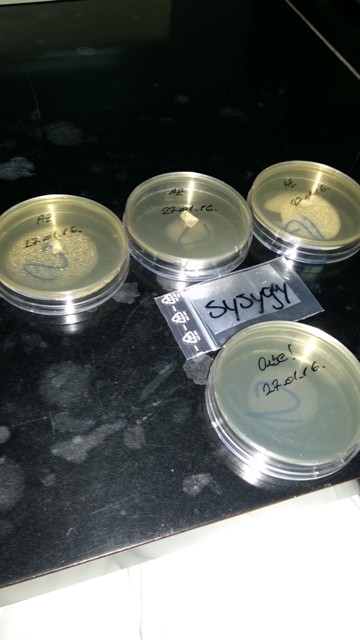
slika

Nakon jako dugo vremena prije dva mjeseca sam na fsre-u uočio da azurescens nije prekrižen tako da sam im istog trena poslao kuvertu, a povratna je stigla prije nekih 10 dana. Mislio sam sačekati neku smjenu gdje mogu to sve obaviti u sterilnim uvjetima na miru ali mi se ne da više čekat, a i sjetio sam se da imam neke PDA petrijevke u fridžu, istina da su stare nekih 5-6 mjeseci ali na njima nema nikakvih tragova kontaminacije tako da bi trebale poslužit za ovu svrhu.
Azurescens je za razliku od cubensisa "woodlover" raste na drvenim supstratima ali o rastu i plodnošenju otom potom jer ove će bebe izrast (ako sve bude po planu) tek negdje u listopadu/studenom 2016
Uzgoj micelija ove vrste je malo zeznutiji iako sam guglajući o azurscensu naišao na jedan dnevnik gdje je lik radio isto sve kao i sa cubensisima, multispore syringe na zrnje i razvio mu se micelij s kojim je zarazio još zrnja ali je imao problema kasnije jer isti nije mogao kolonizirat drveni supstrat. Upozoren sam da ću vjerovatno morati raditi selekciju i izolaciju sektora sa micom ali imam spremnu još jednu petrijevku tako da su to sad trenutno slatke brige
Znači spore su prebačene na agar sa današnjim datumom, radio sam u što je moguće sterilnijim uvjetima (sad sam se sjetio da sam to mogao i odradit na balkonu jer je kolko tolko sve čisto i bijelo)
Htio bih pitati što je sa vodom u ovom slučaju? Da li sam možda trebao kapnuti kap vode na mjesto gdje sam prebacio spore?


ostrugnuo sam samo milimetrić spora sa printa, zatvorio ga i spremio nazad u zipbag

To je to zasad ako sve bude po planu za par tjedana izoliramo mic na novu petrijevku i korak po korak